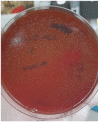

Spreading of Pasteurella multocida Infection in a Pet Rabbit Breeding and Possible Implications on Healed Bunnies
- PMID: 35737353
- PMCID: PMC9229391
- DOI: 10.3390/vetsci9060301
Spreading of Pasteurella multocida Infection in a Pet Rabbit Breeding and Possible Implications on Healed Bunnies
Abstract
The number of pets such as dogs, cats, rabbits, and parrots has increased in European families. Social benefits to owners such as decreasing feelings of loneliness and anxiety are provided by pets which are also used in Animal-assisted Therapy (AAT). Nevertheless, human-animal interactions are also associated with health problems including allergies, asthma, and zoonosis. Rabbits may carry potential pathogens for humans. One of the most common bacteria that colonizes the oro-pharynx and the upper respiratory tract of rabbits is Pasteurella (P.) multocida. Transmission of the infection to humans results from scratches, licks, and bites but it also can occur from the inhalation of air particles containing the microorganism. Immunocompromised people or persons with pulmonary disorders are particularly susceptible to the infection. Infected rabbits may carry P. multocida with or without clinical signs. In this paper, the sensitivity to antibiotics and the invasiveness ability of P. multocida identified in a farm of pet rabbits affected by severe pasteurellosis were investigated. The strain was P. multocida belonging to capsular type A which is the type most often detected in humans. The identified strain was susceptible to the tested antibiotics, but it appeared equipped with several virulence genes which are responsible for fimbriae production, adhesion processes to host cells, enzyme production, and are involved in iron acquisition processes. These findings are of particular interest because rabbits recovered from pasteurellosis very often become carriers of the bacteria. Therefore, we suggest considering P. multocida screening in the routine medical checks of rabbits, especially if they are meant to be companion animals for children and elder people, given that the transmission of the pathogen cannot be excluded.
Keywords: Pasteurella multocida; pet rabbit; vaccine; virulence genes.
Conflict of interest statement
The authors declare no conflict of interest.
Figures

References
-
- Rapporto Assalco-Zoomark ai Tempi del COVID-19. [(accessed on 17 November 2021)]. Available online: https://www.assalco.it/index.php?action=shownews&id=1&nid=10415.
-
- Day M.J. Pet-related infections. Am. Fam. Phys. 2016;94:794–802. - PubMed
-
- Centers of Disease Control and Prevention. [(accessed on 1 July 2021)]; Available online: https://www.cdc.gov/onehealth/basics/zoonotic-diseases.html.
LinkOut - more resources
Full Text Sources
Research Materials
Miscellaneous

